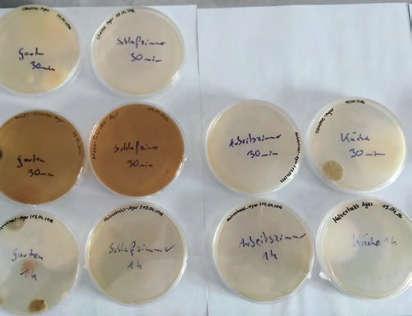

na počátku roku 2020 zažili školáci po celém světě jedno velké překvapení: koronaprázdniny. Jenže na rozdíl od dní, kdy nečekaně odpadne škola kvůli extrémním povětrnostním podmínkám, se z koronaprázdnin nikdo neradoval.











na počátku roku 2020 zažili školáci po celém světě jedno velké překvapení: koronaprázdniny. Jenže na rozdíl od dní, kdy nečekaně odpadne škola kvůli extrémním povětrnostním podmínkám, se z koronaprázdnin nikdo neradoval.
Svět trnul strachy a očekával největší katastrofu od druhé světové války. Příčinou byl virus, který je v porovnání s člověkem velký asi jako myš vůči celé planetě.Jak ale vlastně vzniká nová nemoc, co je to pandemie a proč existuje teprve posledních pár tisíc let? Čím se zabývá mikrobiologie a proč je pro nás tak důležitá? Dokážete si představit, že každá buňka našeho těla obsahuje tisíce organel, které se kdysi vyvinuly z bakterií? Tyto organely fungují jako jakési buněčné elektrárny a říká se jim mitochondrie. Žijí v symbióze se všemi živočichy, rostlinami a houbami, a to dost možná už od doby před více než 2 miliardami let – tedy od doby, kdy ještě neexistovaly žádné mnohobuněčné organismy.
Dokonce i viry, které se ani nepočítají mezi živé organismy a které jsme ještě před pár lety řadili mezi parazity, jsou pro přírodu

nepostradatelné. Virům například vděčíme za to, že se vyvinuli savci.
Většina těchto mikroskopických složek
přírody je nejen neškodná, ale dokonce i nevýslovně užitečná. Stačí si vzpomenout třeba na čistírnu odpadních vod, jeden
z největších lidských vynálezů. Bez těchto wellness oáz pro mikroorganismy bychom se zalkli vlastním odpadem. Ovšem takovíto neúnavní pomocníci nežijí jenom v čističkách, oni jsou také v nás a na nás.
Věděli jste, že naše tělo má více bakterií
než vlastních buněk?
V tomto mírumilovném soužití se bohužel občas něco pokazí a pak vznikají nemoci. Obzvlášť ošemetná situace nastává, když přicházíme do styku s dosud neznámými mikroorganismy a viry. I takové vetřelce
však za normálních okolností zadrží náš imunitní systém. Pokud byste se rádi dozvěděli, jak to celé probíhá, pak doufáme, že si v této knize s chutí počtete!
Autoři této knížky Katrin a Karsten jsou zde vyobrazeni ve velikosti naší planety. Koronavirus je proti nim velký sotva jako malá myška. A teď si zkuste představit, co zlého by tak asi mohla malá myška způsobit naší planetě. Správně – prakticky vůbec nic


Inteligentní bestie mezi viry
Zavřeli školu – a to přitom nebyly prázdniny!
Důvod, který k tomu vedl, vám zpočátku připadal nejspíš dost nepochopitelný: koronavirus. Najednou o něm mluvili všichni a pro dospělé byl všudypřítomným tématem číslo jedna.
Prvních pár dnů bez školy vám určitě připadalo bezva. Ale pak vám asi začali chybět kamarádi a vadilo vám, že nemůžete chodit na kroužky. Nesmělo se ani za babičkou a za dědou a mluvit s nimi jen po telefonu bylo pro všechny takové divné.
Na počátku roku 2020 děsil koronavirus celý svět. Dne 30. ledna 2020, dlouho předtím, než se zavřely školy, a jen měsíc poté, co byl virus objeven, informovala Světová zdravotnická organizace (WHO) o „globálním stavu zdravotní nouze“. K něčemu takovému dochází jen velmi zřídka!
Od té doby určoval běh našeho každodenního života jeden drobounký patogen: zavřely se nejen školy a restaurace, ale také školky, hřiště, bazény, obchody, muzea, továrny a mnoho dalšího. Leckde byl dokonce vyhlášen zákaz vycházení. Všechna tato opatření se zdají být naprosto šílená, když si uvědomíme, kdo že nás to tu vlastně ohrožuje. Jen se znovu podívejte na obrázek zeměkoule na straně 9.
Vidíte na něm překvapivý poměr. Pokud by byli oba autoři této knihy velcí jako celá naše Země, pak by virus jen stěží dosahoval velikosti malé myšky. Proč se ale něčeho tak malého tak strašně bojíme?
Abychom vám to mohli vysvětlit, chtěli bychom vás zavést do říše mikrobiologie.
Důvodem pro tuto návštěvu je, že svět, jak ho znáte, se všelijakými živočichy a rostlinami, je vlastně jen polovina toho, co na Zemi ve
skutečnosti existuje. Před našima očima totiž zůstává ukrytý ještě jiný svět, který je natolik fantastický, že i ty nejnapínavější historky jsou proti němu vyloženě nuda.
Mikroorganismy a viry mohou
být extrémně nebezpečné a jsou všudypřítomné, ovšem většinou jsou neškodné a nesmírně užitečné.

Na krásném koronaviru není na pohled vidět, jak dokáže
být nebezpečný


Ve skutečnosti existuje celá řada různých koronavirů – odborníci jim říkají čeleď Coronaviridae. Název dostaly už v roce 1968 na základě svého vzhledu, který svým tvarem vědcům připomínal sluneční korónu, tedy světelný prstenec, který vzniká při zakrytí slunce.1
Virus, který otřásl světem počátkem roku 2020, se nazývá SARS-CoV-2 a způsobuje onemocnění covid-19. Tady v knize mu říkáme jednoduše koronavirus

Geniální nanoroboti
Než se pustíte do čtení, musíme uvést na pravou míru jednu věc: na stránce 13 jste viděli parádní obrázek koronaviru. Ale přísně vzato to není tak docela pravda, protože ve vědě se virus pokládá za virus teprve tehdy, když se nachází v hostitelské buňce a v ní se pustí do své často značně destruktivní práce. To, co jste viděli na obrázku, je virion, který je vybaven ochrannou vrstvou, aby dokázal přežít ve volné přírodě. Tento rozdíl je důležitý, protože virion mimo buňku nezmůže prakticky nic. Na povrchu má však drobné struktury, kterým se říká S proteiny (S od slova „spike“, což anglicky znamená „hrot“ nebo „bodec“). S jejich pomocí se viry dokážou zachytit na buňkách živých tvorů
Jenže viriony mají jeden velký problém, protože pomocí těchto S proteinů se dokážou zachytit pouze na velmi specifickém povrchu. Tak třeba koronavirus dokáže dobýt pouze
povrchy s tzv. ACE2 receptory. Tyto receptory jsou bohužel přítomny na tělních buňkách mnoha orgánů, jako jsou plíce, srdce, nosohltan, ledviny, žaludek a střeva.
Obzvláště velké množství jich je na plicních buňkách, a proto může koronavirus vyvolat zápal plic. Dalším příkladem je virus klíšťové encefalitidy. Ten dokáže zakotvit pouze na nervových buňkách a může způsobit zánět mozkových blan. Tyto viry byste si klidně mohli bez obav vzít do ruky a hrát si s nimi.
Nebyly by ničím jiným než neživými zrnky prachu, jen mnohem menší. Pokud se ale tato zrnka prachu dostanou na správnou buňku, pak se na ní zachytí.
Jakmile se jim to podaří, následuje krok 2: viriony jako by měly k buňce klíč a dokázaly ji tím klíčem jednoduše „odemknout“. Hned jak to udělají, vnesou do buňky svou RNA či DNA s návodem na výrobu dalších virů. Tím
pro viry začíná jejich zásadní poslání: pomocí
vlastních pomocných proteinů převezmou
kontrolu nad buňkou. Nyní jsou tu pánem
viry a z buňky si udělají líheň svých potomků
Jakmile je výroba virů dokončena, je výsledný

Princip klíče a zámku
produkt uvolněn z hostitelské buňky ve formě virionu. Infikované buňky přitom mohou dokonce prasknout. Vědci tomuto procesu říkají lytický cyklus
Zhruba takto vypadá rozříznutý koronavirus. Spirála uprostřed je RNA s návodem na výrobu viru.

Jak název napovídá, něco zde zapadá do něčeho jiného. K tomu je zapotřebí
vědět, že každá biologická buňka je obklopena membránou (viz kapitola Jak vznikl život). Tato membrána funguje podobně jako naše kůže. Buňky ale musejí nějak komunikovat s okolním prostředím. V tom jim pomáhají proteiny. Jsou něco jako malé
stroječky, které vykonávají určité práce, něco stavějí nebo něco přepravují z bodu A do bodu B. A podle toho, jakou zastává stroječek funkci, má také určitý tvar, podobně jako třeba i traktor vypadá jinak než vrtačka. Plicní buňka má na svém povrchu speciální proteiny, které mají také jedinečný tvar, do kterého přesně zapadají S proteiny virionů
Princip zámku a klíče najdete také na stránkách 116–121 v pasáži o antigenech a protilátkách.



Odborníci dokážou znečištění vzduchu v domácnosti celkem snadno
odhalit: vezmou si malé ploché mističky (takzvané Petriho misky) s gelem, který obsahuje živné médium (živiny, na nichž si plísně rády smlsnou), a několik minut je nechají otevřené na vzduchu. Poté misky uloží na týden na teplé místo. Po týdnu spočítají plísňové kolonie, které se na živném médiu vytvořily. Aby se zjistilo, kde je v bytě plísňová koncentrace nejvyšší, umístí odborník misky do sklepa, do obývacího pokoje nebo na balkon a později výsledky porovná. Stejným způsobem jsme postupovali i my (viz obrázky) a Robert Koch (viz kapitola Cestování v čase do historie objevů).

Nejvyšší znečištění vzduchu bývá v kuchyni. Tamní vlhkost a dostatek výživy představují pro mikroorganismy dokonalé životní podmínky. Proto by se tu neměly povalovat žádné staré potraviny a povrchy v kuchyni by měly být suché.

Zde můžete vidět, kde se vyskytují choroboplodné zárodky ve vzduchu u nás doma. Většinu z nich jsme zachytili na zahradě (tři misky vlevo). V pracovně a v ložnici nebylo prakticky nic. Několik kolonií vybujelo jen v miskách, které jsme otevřeli v kuchyni. Některé misky jsme nechali otevřené hodinu, jiné 30 minut.

Tyto krásné kolonie jsme našli ve sklepní místnosti, kde máme uložená čerpadla. Je to taková vyzděná jáma, ve které se do domu čerpá dešťová voda a z domu odčerpává voda odpadní. V této místnosti je vždy příjemné vlhko, ideální klima pro plísně. Pro lidi je takové klima škodlivé, ale našim čerpadlům je to naštěstí úplně jedno.



Zní to jako pohádka!
V kapitole o virech jste si všimli, že není vůbec snadné popsat, co to život vlastně je. Pokud je obtížné už to, jak to asi teprve vypadá s otázkou:
Jak vznikl život? Přesně to neví nikdo, ale rádi bychom vám v pěti krocích vysvětlili, jak si většina vědců v současné době vznik života představuje. Celé jsme to hodně zjednodušili.
Abyste skutečně pochopili všechny reakce, museli byste strávit mnoho let studiem chemie, biologie a fyziky. Následující etapy vám tedy mají poskytnout pouze přibližnou představu.
ŽIVOTA NA ZEMI
Dva američtí vědci Stanley Miller a Harold Clayton Urey provedli na univerzitě v Chicagu v roce 1953 průkopnický experiment: věděli, jaké složení měl vzduch asi před čtyřmi miliardami let a jaké podmínky tehdy panovaly na Zemi. A toto prostředí se pokusili

reprodukovat ve velké skleněné baňce.
Baňkou sršely blesky, všechny složky směsi se zahřívaly a ochlazovaly (chemická evoluce).
Vědci tomuto prostředí říkají prapolévka nebo také prebiotická či primordiální polévka.
Důležitou součástí této „polévky“ byl metan, nejjednodušší molekula uhlovodíku.
Veškerý život, který známe, je tvořen uhlovodíky.
Molekula metanu má velmi jednoduchou
strukturu: skládá se pouze z jediného atomu uhlíku a čtyř atomů vodíku. Proto se taky nazývá uhlovodík. Velmi dobře hoří, a proto se běžně spaluje v kuchyních s plynovými sporáky. Po provedení experimentu byli vědci ohromeni, protože pětina (20 %) metanu se přeměnila v mnohem složitější molekuly: vznikly organické sloučeniny, a tím byl vytvořen chemický základ pro vznik prvních živých organismů



Písmenem C se značí atom
uhlíku a písmenem H atom vodíku. Pokud se atomy spojí, hovoříme o molekule.
Prapolévka byla na počátku veškerého života na Zemi
Zatím v ní ještě nic nežilo, ale obsahovala všechny složky, které jsou k životu potřeba.
Problém, který jsme si způsobili sami
Po většinu lidských dějin žádné pandemie neexistovaly. Naši předkové samozřejmě také trpěli nemocemi, můžeme je dokonce vysledovat v zubním kameni lidí z doby kamenné. Jenže tehdy lidé žili v malých oddělených skupinách, a tak se nemoci nemohly tak dobře šířit. Velké skupiny by v přírodě jednoduše nenalezly dostatek potravy. Ovšem naši předkové si byli nemocí velmi dobře vědomi. Stejně jako některá další zvířata byli dokonce obeznámeni s lékařskými protiopatřeními (ale o tom více v kapitolách Hygiena, Očkování a Léky).
Se vznikem prvních stálých osad před
10 000 lety a počátkem zemědělství byl vynalezen také obchod na větší vzdálenosti. Kdyby patogeny uměly jásat, tak by to nejspíš


bujaře oslavily! Konečně se totiž mohly
šířit nejen v malé populaci. Díky obchodu a cestování se jim najednou otevřel celý svět.
Pravděpodobně nejznámější pandemickou chorobou je mor (viz infobox). Nejvíce informací máme o třetí morové pandemii, protože k ní došlo jen o něco více než před 100 lety. Vypukla v Číně, stejně jako pandemie koronaviru. Odtamtud se rozšířila do celého
světa. Jak jste se již dozvěděli v kapitole Cestování v čase do historie objevů, působilo v Evropě v té době mnoho vědců, kteří se zabývali mikrobiologií. Jejich znalosti byly v boji proti moru využity, a tak byla Evropa nejhoršího ušetřena. Podle dokumentů z tohoto období zemřelo v Evropě na mor pouze 457 lidí. Mezinárodní spolupráce, důsledné dodržování karanténních opatření a obecně lepší hygiena tak zachránily život pravděpodobně milionům Evropanů
Lidé si dříve mysleli, že mor přenášejí krysy. Ale není to pravda. Hlodavci sice mohou být nositeli moru, ale ten se přenáší kousnutím blechy. Žádné blechy = žádný mor, někdy je to takhle jednoduché.14 Jakmile však mor jednou propukne, může se přenášet kapénkovou infekcí i z člověka na člověka.


Mor vyvolaný bakterií Yersinia pestis způsobil nejméně tři velké pandemie:

justiniánský mor v 6. století: někteří vědci se domnívají, že ve Východořímské říši zemřela až polovina populace;

„černou smrt“ ve 14. století: tato pandemie trvala sedm let a o život připravila na 25 milionů lidí – třetinu tehdejší populace;

při třetí morové pandemii na konci 19. století zemřelo na celém světě přes dvanáct milionů lidí
Pozor: Mor ještě nebyl zcela vymýcen, v červenci 2020 propukl na severu Číny.

Ukázkový příklad udržitelnosti
Jen si to přiznejme: mobilní telefony, počítače i auta jsou skvělé věci. Ovšem vskutku geniální vynález, na který lidé přišli, je čistírna odpadních vod (čistička). Ano, opravdu čtete správně. Máme na mysli ona skrytá průmyslová zařízení na krajích měst, která shromažďují vše, co spláchneme do záchodu. Víte vlastně, kde se ve vašem městě čistírna odpadních vod nachází? Pravděpodobně ne, protože většina lidí nechce ani vědět, kam směřuje páchnoucí voda z jejich odpadního potrubí. Dáme vám malou nápovědu: protéká-li vaším městem řeka, je čistírna odpadních vod vždy za městem po směru proudu. Ptáte se proč? Nikdo přece nechce, aby odpadní voda z čistírny protékala městem. Přitom by to vůbec nevadilo. Karsten si během studií přivydělával jako výzkumný potápěč a pravidelně se potápěl u výstupního potrubí čistírny odpadních vod Bülk poblíž Kielu. Oceánografický institut chtěl zjistit, zda čistírna odpadních vod ovlivňuje život rostlin
a živočichů v Kielské zátoce, která je součástí
Baltského moře. Zjistilo se, že neovlivňuje. Voda tam byla natolik čistá, že dokonce ani plavci si vůbec nevšimli, že je poblíž čistírna.
Abyste pochopili, jak se z nechutné odpadní vody našeho kanalizačního systému může znovu stát voda čistá, musíme vás vytáhnout do přírody. Určitě jste už slyšeli, že v přírodě všechno funguje v kolobězích. Možná znáte koloběh vody: voda se nad mořem odpařuje, v podobě mraků se dostane nad pevninu, tam se vyprší, steče se do řek a jimi proudí zpět do moře. Takový koloběh existuje i u organického materiálu, tedy u zbytků rostlin a živočichů
V biologii se tento koloběh dělí do tří oblastí. První oblast patří rostlinám. Ty čerpají ze vzduchu oxid uhličitý a z půdy živiny a vodu, z nichž produkují za pomoci slunečního světla biomasu (organické sloučeniny, jako je třeba cukr). Proto jim říkáme producenti.
Do druhé oblasti spadáme my lidé a všichni
ostatní živočichové. Živíme se rostlinami, které našemu tělu dodávají energii nebo které
naše tělo využívá jako stavební materiál pro nové buňky. Místo „živíme se“ bychom také mohli říct, že „konzumujeme“, a proto se druhá skupina nazývá konzumenti.
Tento koloběh se samozřejmě musí znovu
nějak uzavřít, jinak by se všude povalovaly odumřelé rostliny a mrtvá zvířata.
Bez mikroorganismů bychom se zalkli vlastním odpadem.
Tady vstupují do hry jako třetí oblast rozkladači (destruenti). Jsou to mikroorganismy, které organický materiál rozkládají tak, aby se z něj stal opět materiál anorganický, který může být absorbován rostlinami. Tento proces degradace probíhá ve dvou velkých krocích, jednou s kyslíkem a jednou bez kyslíku. Pokud zahyne nějaký živý organismus, ať už se jedná o rostlinu, živočicha, houbu, nebo bakterii, spadnou jeho zbytky (biomasa) na zem a zůstanou tam ležet. To se děje všude, na vaší zahradě, v lese, na poli, ale také ve vodě, v řekách, jezerech a mořích.

Věčný koloběh přírody
